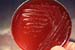

Página
1 de 5 |
| Curso de Enfermedades Infecciosas Porcinas Galería Fotográfica - Otras Enfermedades Bacterianas |
Página
1 de 5 |

|
|

|

|

|
| Aborto | Agar | Aislados | Ambiente | Bacterias |

|

|

|

|

|
| Bovituber | Brucelas | Brucelosis | Brucelosis-2 | Brucelosis-3 |